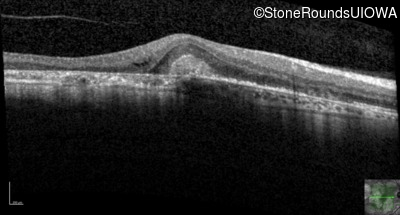
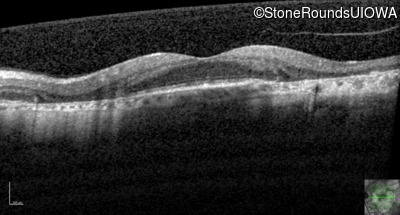
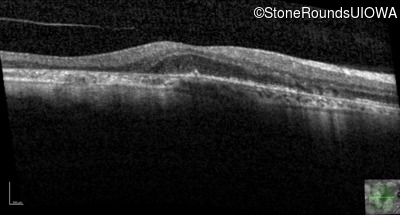
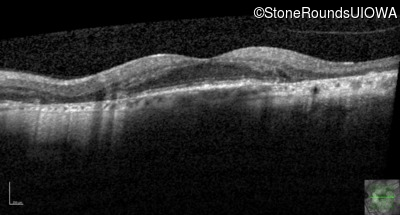
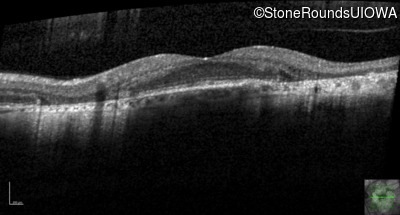
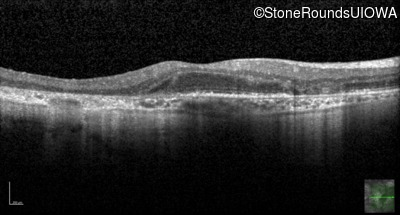
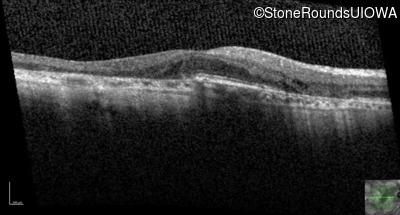
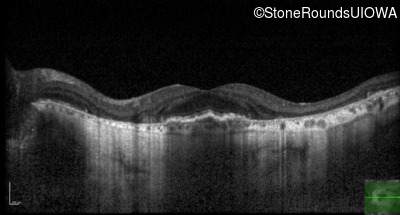
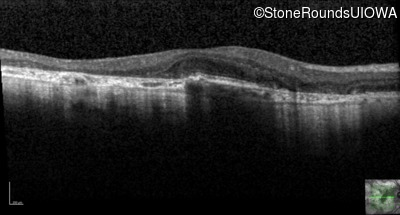
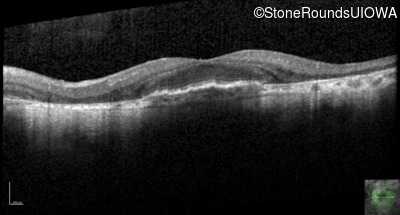
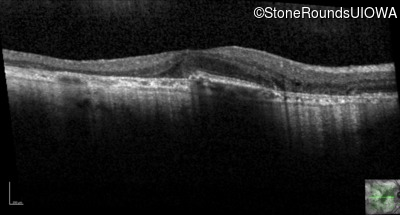
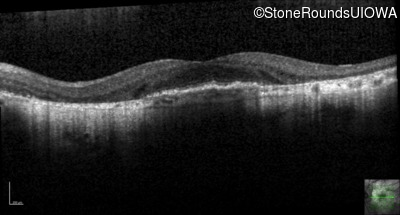
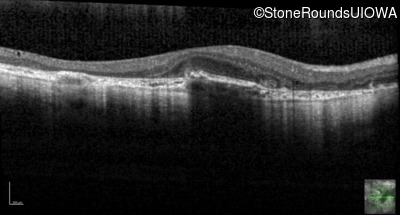
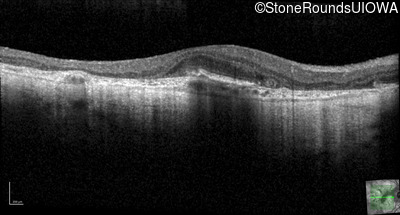
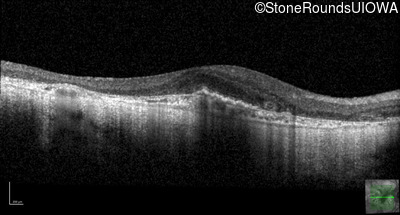
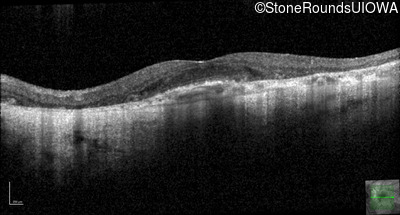
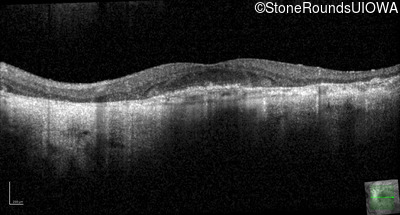

Case
SR1471
Student Mode
AR Stargardt Disease (IIA)
Female
Female
Hidden
SR1471
Student Mode
AR Stargardt Disease (IIA)
Female
Female
History
This 51 year old woman first experienced some abnormality in her distance vision when she was 27 years old. She feels that her vision has been stable since that time.
| Age at visit: 54 years (Visit 2) |
| OD | OS | ||
|---|---|---|---|
| Age at visit: 55 years (Visit 2) |
| OD | |||
|---|---|---|---|
| OD | |||
|---|---|---|---|
| Age at visit: 57 years |
| Age at visit: 58 years |
| Age at visit: 59 years |
| OD | OS | ||
|---|---|---|---|
| OD | OS | ||
|---|---|---|---|
| OD | OS | ||
|---|---|---|---|
| Age at visit: 61 years |
| Age at visit: 62 years |
| OS | |||
|---|---|---|---|
| Age at visit: 64 years |
Diagnosis & molecular findings
| Disease | Gene | Allele 1 variant(s) | Allele 2 variant(s) | Inheritance mode |
|---|---|---|---|---|
| AR Stargardt Disease | ABCA4 | Gly1507Arg GGG>AGG | IVS42+1 G>A | AR |
Disease:
Gene:
Allele 1:
Gly1507Arg GGG>AGG
Allele 2:
IVS42+1 G>A
Inheritance:
AR